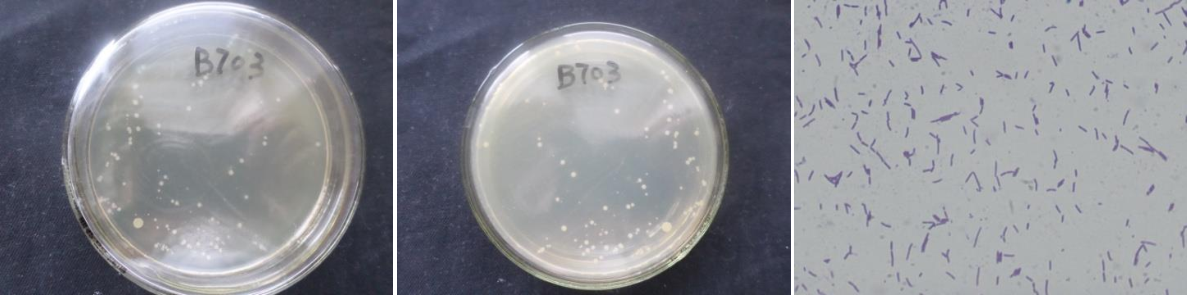

Loading...
| StrainNO | B703 |
| Classification | Bacillus |
| 16s rDNA sequence | CTCCAAAAGGTTACCCCACCGACTTCGGGTGTTACAAACTCTCGTGGTGTGACGGGCGGTGTGTACAAGGCCCGGGAACGTATT CACCGCGGCATGCTGATCCGCGATTACTAGCGATTCCGGCTTCATGCAGGCGAGTTGCAGCCTGCAATCCGAACTGAGAATGGT TTTATGGGATTCGCTTAACCTCGCGGTCTCGCAGCCCTTTGTACCATCCATTGTAGCACGTGTGTAGCCCAGGTCATAAGGGGC ATGATGATTTGACGTCATCCCCACCTTCCTCCGGTTTGTCACCGGCAGTCACCTTAGAGTGCCCAACTGAATGCTGGCAACTAA GATCAAGGGTTGCGCTCGTTGCGGGACTTAACCCAACATCTCACGACACGAGCTGACGACAACCATGCACCACCTGTCATCCTG TCCCCCGAAGGGGAACGCCCTATCTCTAGGGTTGTCAGGAGATGTCAAGACCTGGTAAGGTTCTTCGCGTTGCTTCGAATTAAA CCACATGCTCCACCGCTTGTGCGGGCCCCCGTCAATTCCTTTGAGTTTCAGCCTTGCGGCCGTACTCCCCAGGCGGAGTGCTTA ATGCGTTTGCTGCAGCACTAAAGGGCGGAAACCCTCTAACACTTAGCACTCATCGTTTACGGCGTGGACTACCAGGGTATCTAA TCCTGTTTGCTCCCCACGCTTTCGCGCCTCAGCGTCAGTTACAGACCAAAGAGTCGCCTTCGCCACTGGTGTTCCTCCACATCT CTACGCATTTCACCGCTACACGTGGAATTCCACTCTTCTCTTCTGCACTCAAGTTCCCCAGTTTCCAATGACCCTCCCCGGTTG AGCCGGGGGCTTTCACATCAGACTTAAGGAACCGCCTGCGCGCGCTTTACGCCCAATAATTCCGGACAACGCTTGCCACCTACG TATTACCGCGGCTGCTGGCACGTAGTTAGCCGTGGCTTTCTGGTTAGGTACCGTCAAGGTACCGGCAGTTACTCCGGTACTTGTTCTTCCCTAACAACAGAGTTTTACGATCCGAAAACCTTCATCACTCACGCGGCGTTGCTCCGTCAGACTTTCGTCCATTGCGGA AGATTCCCTACTGCTGCCTCCCGTAGGAGTCTGGGCCGTGTCTCAGTCCCAGTGTGGCCGATCACCCTCTCAGGTCGGCTACGC ATCGTTGCCTTGGTGAGCCGTTACCTCACCAACTAGCTAATGCGCCGCGGGCCCATCTGTAAGTGATAGCCGAAACCATCTTTC AGCTTTCCCTCATGTGAGGGAAAGAATTATCCGGTATTAGCCCCGGTTTCCCGGAGTTATCCCAGTCTTACAGGCAGGTTGCCC ACGTGTTACTCACCCGTCCGCCGCTGACTTCAGGGAGCAAGCTCCCATCAGTCCGCTCGACTT |
| Strain Morphology Photos | |
| Morphological Description | The morphology of Colony round;lychee white;edge serrated;flat;convex in the middle;slippy;sticky;The morphology of strain:Rod;having spore;bias in budding spores |